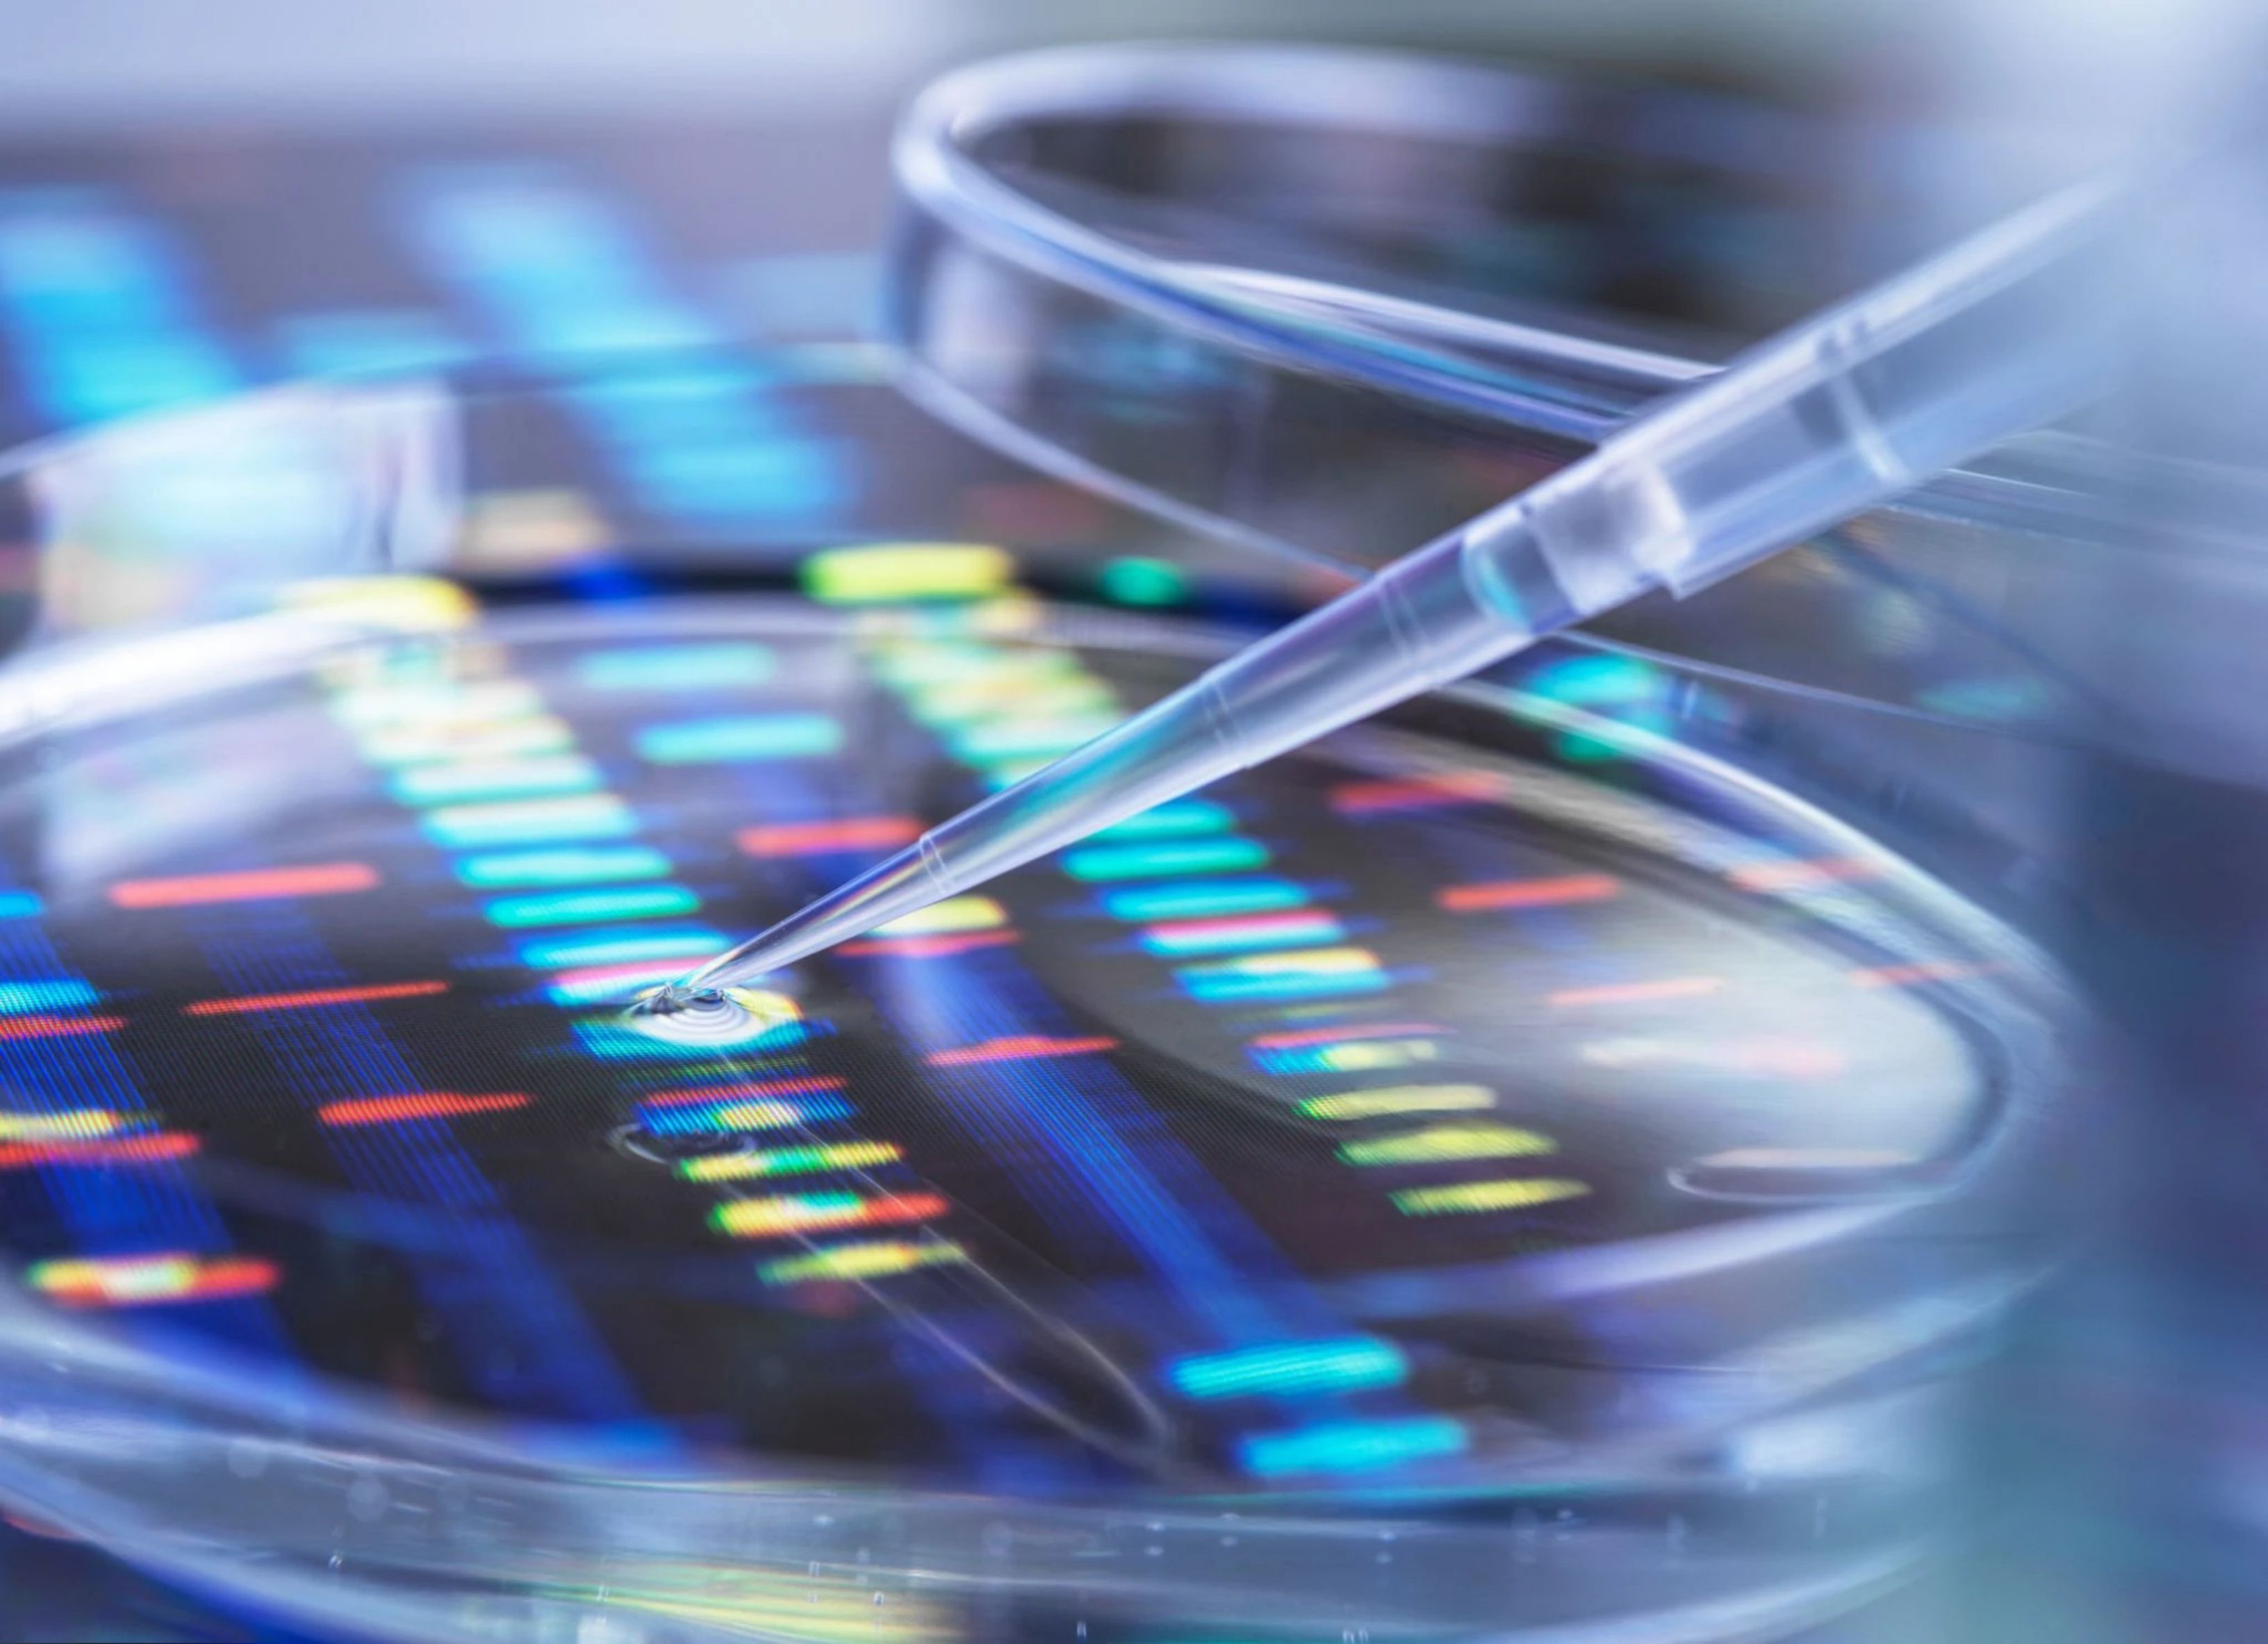
genetic testing

The Role of DNA Psychotropic Testing in Personalized Psychiatry
Understanding DNA Psychotropic Testing
DNA psychotropic testing is transforming the field of psychiatry by offering a personalized approach to mental health treatment. This innovative process involves analyzing a patient's genetic makeup to determine how they might respond to different psychiatric medications. The goal is to tailor treatments to the individual, potentially improving efficacy and minimizing side effects.
Traditionally, psychiatric treatment has largely relied on a trial-and-error approach. While this can eventually lead to effective treatment, it often involves a lengthy process that can be frustrating for both patients and clinicians. DNA psychotropic testing aims to streamline this process by providing insights into how a patient may metabolize certain medications and predicting their sensitivity to various drug options.
The Science Behind DNA Psychotropic Testing
The foundation of DNA psychotropic testing lies in pharmacogenomics, the study of how genes affect a person's response to drugs. By examining specific genetic markers, clinicians can make informed decisions about which medications might work best for a particular patient. For example, variations in genes like CYP2D6 and CYP2C19 can influence how quickly or slowly a person metabolizes certain drugs, affecting their overall response to treatment.
This genetic information is gathered through a simple test, often using a saliva sample. The sample is then analyzed in a laboratory, and the results are used to guide the psychiatrist's choice of medication. This approach not only has the potential to enhance treatment outcomes but also reduces the trial-and-error period, providing relief more swiftly to those in need.
Benefits of Personalized Psychiatry
Personalized psychiatry through DNA psychotropic testing offers several significant benefits:
- Improved Treatment Accuracy: By tailoring medication choices based on genetic information, there is a higher chance of selecting an effective treatment from the start.
- Reduced Side Effects: Understanding a patient's genetic profile can help avoid medications that are likely to cause adverse effects.
- Faster Symptom Relief: As the trial-and-error period is shortened, patients may experience quicker relief from their symptoms.

Challenges and Considerations
Despite its promise, DNA psychotropic testing is not without challenges. One primary concern is the cost, as genetic tests can be expensive and may not always be covered by insurance. Additionally, there is a need for more research to fully understand the implications of certain genetic markers on psychiatric medication responses.
Ethical considerations also come into play, particularly regarding patient privacy and the potential misuse of genetic information. It is crucial that patients are fully informed about the testing process and its implications, ensuring that their consent is obtained transparently and ethically.
The Future of Psychiatry
The integration of DNA psychotropic testing into psychiatric practice represents a significant shift towards personalized medicine. As research continues to evolve, the hope is that this approach will become more accessible and affordable, benefiting a larger population of patients.

While it may not replace traditional methods entirely, DNA psychotropic testing offers a promising complement to existing psychiatric practices. By combining genetic insights with clinical expertise, mental health professionals can provide more targeted and effective care, ultimately improving outcomes for many individuals dealing with mental health challenges.
As we continue to explore the potential of this technology, it becomes increasingly clear that personalized psychiatry is paving the way for a new era in mental health treatment. With ongoing advancements and increased understanding, the future looks bright for those seeking more individualized approaches to managing their mental health.
